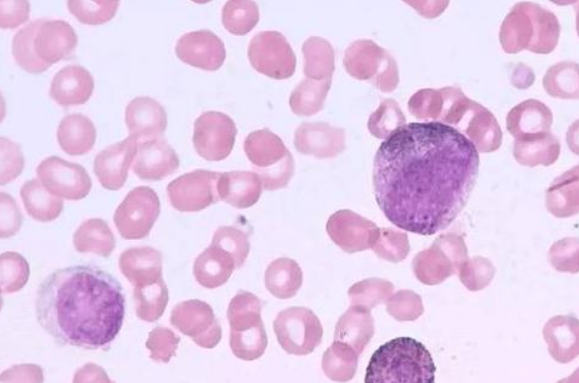

诱导治疗失败或复发的患者基本上有两种治疗选择。额外的化学疗法很少能治愈,有些患者会选择姑息疗法,即以无毒剂量服用药物,以尽可能长时间地控制疾病。在这种情况下,重点是生活质量和支持性护理措施。
许多慢粒患者提出了疑问:自从服药后,身体没有任何感觉,血常规正常。为什么需要一直检查血液和骨骼磨损?
血液疾病专家说,即使是轻微的症状也不能忽视慢性粒细胞白血病是一种恶性疾病的事实。患者服药后需要定期检查血液或骨髓穿刺的主要原因如下:
伊马替尼/伊马替尼的治疗反应逐渐从三个层次获得:血液学、细胞遗传学和分子反应。治疗反应的加深意味着体内白血病负荷逐渐减少。慢性粒细胞白血病的最终治疗目标是停止治疗的持续缓解。目前停止TKI研究的前提是获得连续的深分子反应。
正常血常规仅代表血液学的治疗反应。接受伊马替尼治疗的慢性粒细胞白血病-慢性胰腺炎患者通常在3个月内获得完全的血液缓解。传统的羟基脲和干扰素也能维持慢性粒细胞白血病患者的血液学正常水平,但由于缺乏更深层次的细胞遗传学和分子反应,慢性粒细胞白血病的病程不能得到根本改变。
完整的细胞遗传学反应通常在治疗后12个月内获得,细胞遗传学反应的评估需要分析骨髓细胞的染色体核型。除了常规的G显带染色体核型分析外,通过免疫荧光平面杂交(FISH)检测BCR-ABL融合基因也常用于确定获得完全细胞遗传学应答。
分子反应需要定量检测BCR-ABL进行评估。因此,对于血常规正常的患者,仍需进行骨髓细胞的核型分析和BCR-ABL的定量检测。
综上所述,对于慢粒患者,不仅要注意自身的体征或血常规结果,还要结合自身情况定期做进一步的病情监测,避免延误疾病治疗。